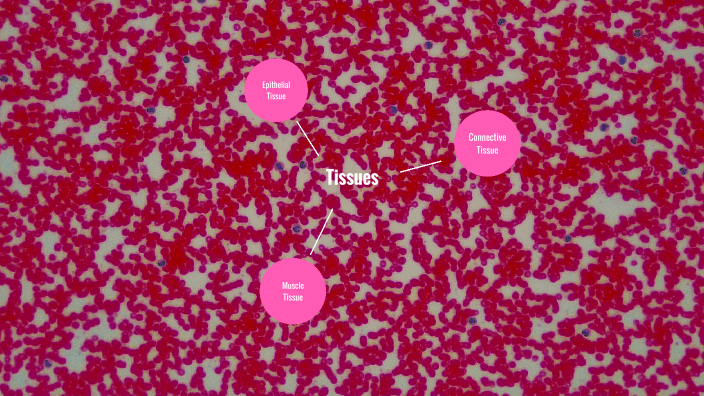
tissue concept map by Marin Bryant on Prezi

In addition to the information above, here is a curated collection of images related to Tissue Types By Amya Barnes On Prezi.
- Tissue Concept Map By Marin Bryant On Prezi
- Amya C. Barnes - Spelman College - Atlanta, Georgia, United States ...
- Tissue | PPTX
- Amya C. Barnes On LinkedIn: Enjoyed The Opportunity Recently To ...
- The Pancreas By Amya Lewis On Prezi
Find More About "Tissue Types By Amya Barnes On Prezi"
Explore exclusive offers, detailed information, and related services about tissue types by amya barnes on prezi from our trusted partners.
View Special Offers